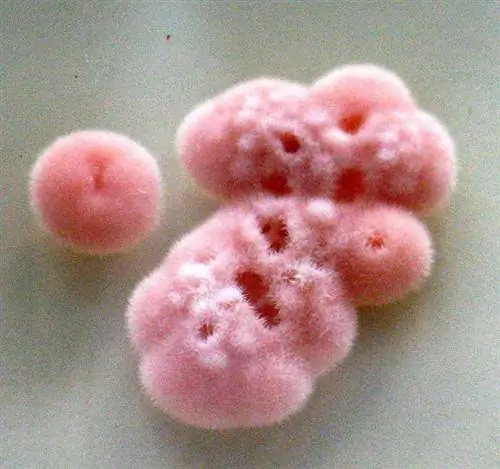
изображение

Прилежный партнер: Астра татарская известна своими лечебно-активными компонентами, но, по-видимому, растение не производит эти лекарства самостоятельно, а, как теперь выяснили исследователи, за их производство отвечает грибок. Он живет в соцветиях астр, но может выращиваться и самостоятельно от них. Это открывает возможность коммерческого производства активных ингредиентов растения.
В ходе эволюции природа создала множество потенциальных лекарств - в частности, растения часто содержат вещества, обладающие лечебным эффектом. Астра татарская (Aster tataricus), например, давно известна как лекарственное растение в традиционной китайской медицине, и современные медицинские исследования теперь также интересуются этим растением. Причина: астра производит так называемые астины, которые связываются с важным человеческим белком-регулятором. Это может позволить им подавлять иммунные реакции и ингибировать рост опухоли.
Pilz как продюсер
Но, как оказалось, эти интересные соединения астра татарская не производит сама, а из гриба, который живет в тканях ее соцветий. Томас Шафхаузер из Тюбингенского университета и его коллеги сделали это удивительное открытие, когда искали способ биотехнологического производства природных веществ.
«Чтобы разработать такой процесс, вы должны знать задействованные гены и метаболический путь, посредством которого образуется природное вещество», - объясняет Шафхаузер. Поэтому ученые более внимательно изучили астру и ее астины и обнаружили, что последняя имеет необычное и сложное химическое строение. «Сравнения с частично подобными природными веществами показывают, что продуцентами астина являются бактерии или грибы», - сообщает исследователь.
Выращивается самостоятельно
На следующем этапе ученым действительно удалось найти производителя. Они выделили грибок Cyanodermella asteris из соцветий растения и культивировали его независимо от растения-хозяина в питательном растворе. При этом Шафхаузер и его коллеги не только обнаружили, что микроорганизм продолжает производить большое количество астина. Они также идентифицировали сегменты ДНК в его геноме, отвечающие за структуру природного вещества - важную предпосылку для коммерческого производства.
Но удивительно: эксперименты показали, что астины больше не производят астины без своего грибкового партнера. Однако, наоборот, грибок также, по-видимому, зависит от своего растения в отношении производства определенных вариантов этих веществ. Например, астры, живущие с их грибком, содержали астин А. Однако, когда гриб культивировался отдельно, он не производил это конкретное соединение.
Выгодная командная работа
«Мы предполагаем, что грибок и растение работают вместе в симбиозе к взаимной выгоде и что растение дает сигнал для производства астина А или само перерабатывает астин из гриба», - объясняет ко- автор Линда Ян из Технического университета Дрездена.
Такие межвидовые метаболические пути, которые требуют сотрудничества двух или более биологических партнеров, практически не изучены.«Они могут быть широко распространены, но мы слишком мало знаем об этом», - говорит ученый. В случае с астрой татарской неясно, в какой степени комплексное вещество Астин приносит пользу. Например, он может играть роль в защите от хищников или патогенов.
